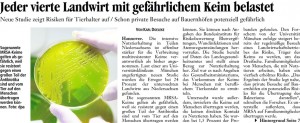

Zitat von Mahatma Gandhi
"Die Größe und der moralische Fortschritt einer Nation lassen sich daran ermessen, wie sie die Tiere behandelt ....."Kategorien
- AbL (Arbeitsgemeinschaft bäuerliche Landwirtschaft) (173)
- Allgemein (778)
- Anfragen (64)
- Bundestag (28)
- Landtag Niedersachsen (36)
- Bauernhöfe statt Agrarfabriken (BsA) (238)
- BUND (40)
- Bürgerinitiativen (377)
- Gefahren (567)
- Brandschutz (205)
- Gesundheit (487)
- Naturschutz (384)
- Tierschutz (446)
- Lebensqualität (499)
- Medien (422)
- Politik (81)
- Bundestag (23)
- Europaparlament (8)
- Landtag Niedersachsen (36)
- Regionsversammlung Region Hannover (2)
- Pressemitteilungen (230)
- Schriftverkehr (55)
-
Neueste Beiträge